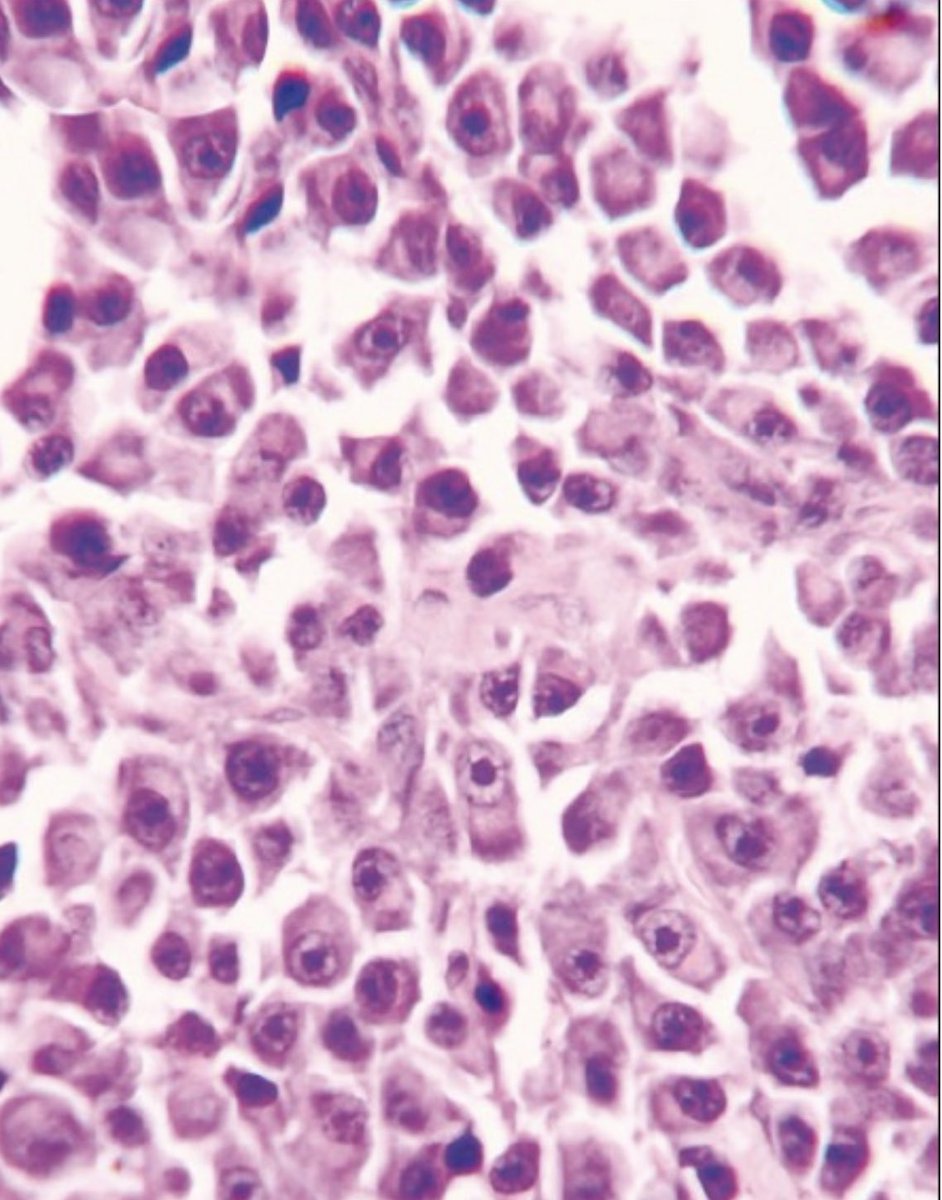
Dr Robert Ayto tweet media

Sabitlenmiş Tweet
Dr Robert Ayto
217 posts

Dr Robert Ayto
@HaemEdDocRob
Haematology Education. Portsmouth Hospitals University Trust. Haematology Consultant. Work with fantastic colleagues. Dog lover. Football fan. All views my own.
Portsmouth Katılım Haziran 2022
442 Takip Edilen806 Takipçiler

60-year-old presents with cytopenias.
Please see the linked questions.
#hematology #MedTwitter #hematology
Reference:- tinyurl.com/5n96xf5v

English

What haematological condition is associated with these X-ray and clinical findings?
#hemepath #hematology #MedEd
See linked question


English

Which cytogenetic is mostly likely to be found in this condition?
See linked poll
#hematology #hemepath #frcpath
English
Dr Robert Ayto retweetledi

Welcome back to the #EHA #ThinkingThursday on diagnostic criteria of #mastocytosis: were your answers correct?

English

Patient presents with pancytopenia - trephine below.
IHC showed cells were CD20 pos, Bcl2 neg, CD10 pos and Bcl6 pos.
What is the diagnosis?
Reference:-
bit.ly/3z3ODOf
#hematology #hemepath #pathology

English

Excellent - active monitoring
Dr Robert Ayto@HaemEdDocRob
The patient underwent bi lateral breast implant removal and total en bloc capsulectomy. There was no capsular penetration and tumour cells penetrated the luminal side of the capsule only. CT PET showed no sites of FDG avid disease. What treatment would you recommend?
English

@HaemEdDocRob RS cell, Classical Hodgkin Lymphoma.
Follow up question, how many patients with advanced stage cHL p/w B symptoms ??
English

Patient presents with night sweats, weight loss, itchiness and anaemia?
Abnormal cells stain for CD15, CD30, EBER and MUM1 but CD45-ve.
What is the cell and diagnosis?
#hemepath #MedTwitter #haematology
#hematology
bit.ly/3zowRq9

English

Correct answer ALK-be BIA Anaplastic - still time to vote on treatment
Dr Robert Ayto@HaemEdDocRob
What is the most likely diagnosis? AL = anaplastic lymphoma HD = Hodgkin disease BIA = Breast Implant Associated
English

Patient presents with splenomegaly, cytopenias and fatigue. A bone marrow was performed. HE below.
What is the likely diagnosis?
#path #oncology #hemepath
bit.ly/3yYIxP0

English

A 56 year old female presents with a left breast Seroma - she has previously undergone bi lateral breast implants. Cytology and immunocytochemistry of a suspicious cell infiltrate is seen below. See thread.
#lymphoma #hemepath #hematology
reference:-
bit.ly/3cE43kI

English


